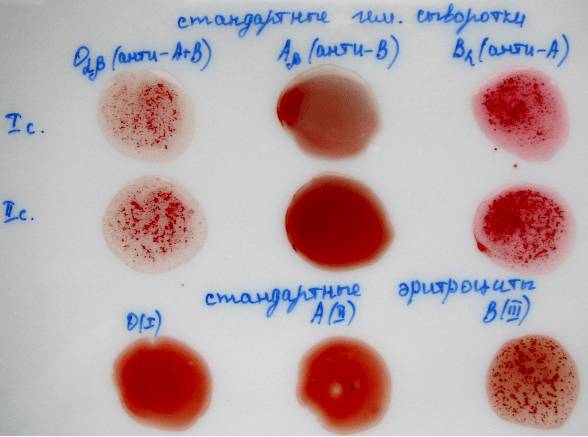

Содержание
Определение группы крови является обязательным параметром для допуска и подготовки к различного рода оперативным вмешательствам. Анализ крови на определение группы важен для возможной ситуации, когда появляется необходимость в переливании реципиенту донорской крови, что особенно важно для военных и служащих схожих сфер.
Методы определения групповой принадлежности
Среди методов определения группы крови выделяют стандартный, метод перекрёстной реакции, при помощи цоликлонов и эритротеста-группокарты.
Групповая принадлежность крови по методике определения группы АВ0 устанавливается на основании реакции агглютинации.
Врачи отмечают, что определение группы крови является важной процедурой, особенно в экстренных ситуациях. Существует несколько методов, каждый из которых имеет свои преимущества и недостатки. Наиболее распространённым является серологический метод, который основан на реакции антигенов и антител. Он обеспечивает высокую точность, но требует лабораторного оборудования и времени.
Совсем недавно появились экспресс-тесты, позволяющие быстро определить группу крови в условиях, где нет доступа к лаборатории. Однако врачи предупреждают, что такие тесты могут быть менее точными. Также существует молекулярно-генетический метод, который позволяет определить группу крови с помощью анализа ДНК. Этот метод считается самым точным, но его стоимость и сложность делают его менее доступным для широкой практики.
Таким образом, выбор метода зависит от конкретной ситуации, доступных ресурсов и необходимости в точности. Врачи подчеркивают, что знание группы крови может спасти жизнь, поэтому важно использовать надежные методы определения.

Стандартный

Процесс анализа происходит путём проведения следующих манипуляций: в пробирку с раствором обычной соли примешивают плазму. Далее набирают в пипетку получившийся раствор и смешивают в другой пробирке с физиологическим раствором. Далее используется планшет, на котором заранее размещают сыворотки. Возле каждой сывороточной капли капают образец, впоследствии смешиваемый с диагностикумом.
В последнее время часто используется более современный способ с применением гелевой методики, в которой происходит коллаборация агглютинации и использования гелевой среды. Для этого применяются специальные диагностические карточки с микропробирками, в которых и содержится нужный гель. Он может иметь нейтральную среду или содержать антитела и реагенты. Далее микропробирки подвергаются центрифугированию, в процессе которого агглютинированные эритроциты оседают на поверхности колонки с гелем.
Остальные эритроциты выпадают на дно.
По прошествии времени выдержки (около 5-ти минут) анализируют результаты, которые могут быть следующими:
- Если агглютинация не наступила со всеми стандартными сыворотками – кровь I группы;
- Если агглютинация наступила только с сыворотками O(I) и B(III) — кровь II группы;
- Если агглютинация наступила только с сыворотками O(I) и A(II) – кровь III группы;
- Если агглютинация наступила со всеми тремя сыворотками — кровь предположительно IV группы, но велика вероятность панагглютинации. Поэтому анализ дополняют четвёртой сывороткой AВ0, если после этого агглютинация не происходит, кровь причисляют к IV группе.
Метод перекрёстной реакции
В данном способе определения группы крови используются как стандартные сыворотки, так и цоликлоны в смеси с эталонными эритроцитами. Её исполнение фактически идентично предыдущей технике, но с некоторыми поправками.
На планшетную поверхность для определения группы крови наносятся сыворотки, а после этого прибавляются эталонные эритроциты.
Далее на планшет наносится плазма пациента, к эталонным эритроцитам, а эритроциты, осевшие на дно – к сывороткам.
Выжидается время и анализируются результаты:
- При наступлении агглютинации в двух каплях – группа I;
- Если агглютинация не наступила ни в одной из капель – группа IV;
- Если реакция наступила в каком-либо эталонном эритроците, далее группа определяется по свёртываемости в капле (её наличию или отсутствию).
Определение группы крови — важная процедура, о которой говорят многие. Люди отмечают, что традиционные методы, такие как реакция с сыворотками, остаются наиболее надежными. Однако с развитием технологий появились и новые способы, например, использование тест-полосок и автоматизированных анализаторов. Некоторые пользователи делятся опытом использования домашних наборов, подчеркивая их удобство, но также предостерегают от возможных ошибок. В социальных сетях активно обсуждаются и мифы о группах крови, например, о влиянии на характер или совместимость в отношениях. В целом, интерес к этой теме растет, и многие стремятся узнать больше о своем здоровье и наследственности.
![[физиология] — Группы крови (AB0), Резус фактор (Rh) и переливания крови](https://i.ytimg.com/vi/xrPrHRFB1qE/maxresdefault.jpg)
Способ с применением цоликлонов
Данный алгоритм определения группы крови проводится зачастую в том случае, когда стандартные сыворотки неприемлемы или при исследовании крови другими способами возникли ошибки.
Метод усложняется требованиями к его проведению.
Температура в лаборатории не должна превышать 25 градусов, освещение должно быть обильным и правильно расположенным. Реагенты должны содержаться в закрытом состоянии, их высыхание уменьшает активность антител. Не используются мутные реагенты или реагенты с примесями. Для каждого реагента используется строго своя пипетка. Также для анализа применяется тарелка со смачиваемой белой поверхностью.
На планшетную поверхность наносят массивные капли цоликлонов с пометками об их виде, далее к ним прибавляют по капле крови и анализируют полученные результаты спустя 3-5 минут.
Расшифровка результата следующая:
- При отсутствии реакции агглютинации во всех полученных каплях, когда в наличии нет антигенов А и В — значение выставляется для I группы;
- При наличии реакции только в одной капле (анти-А), когда в наличии антиген А, значение выставляется для II группы;
- При появлении реакции только в одной капле (анти-В), когда присутствует антиген В, значение выставляется для III группы;
- При наличии реакции в обеих каплях, когда в наличии оба антигена, значение выставляется для IV группы, итоги перепроверяются.
Препараты, которые используются для данного анализа на определение группы:
- Обычный анти-D-цоликлон, используется для непрямой реакции;
- Супер-анти-D-цоликлон, используется для прямой реакции;
- Анти-D-микс, совмещающий предыдущие два препарата, используется как для выявления группы, так и резус-фактора.
Посмотрите видео на эту тему

Эритротест-группокарт
Ещё одним способом определения группы крови является применение эритротестов.
Они менее распространены, но в последнее время стали широко внедряться в практику домашнего использования.

Обычно в комплект набора входит планшет со специальными углублениями для образцов, скарификатор (игла для прокола пальца), стерильная пипетка, в которую происходит забор материала, и набор палочек из стекла для перемешивания содержимого лунок.
С помощью подобного теста можно определить не только принадлежность к группе крови, но и узнать свой резус-фактор.
Алгоритм определения группы крови данным способом построен на использовании вышеуказанных цоликлонов, заранее нанесённых на дно каждой лунки и высушенных для удобства использования. Подготовка набора для определения группы крови состоит в записывании данных исследуемого пациента, нанесении капель воды в каждую из лунок, чтобы привести реагенты в «рабочее» состояние. Далее у пациента забирается кровь и наносится в лунки, перемешивается входящими в комплект палочками. Предварительно кровь наносится на пустое место, не затрагивающее лунки, и уже оттуда разносится разными палочками в каждую лунку отдельно, чтобы избежать загрязнения реагентами и не допустить ошибок. Результаты сравниваются с содержащейся в тесте карточкой с возможными результатами спустя 3-5 минут. Далее можно записать результаты в карточку и сохранить её.
Помимо эритротеста для домашнего использования существуют и иные аппараты, помогающие в определении группы крови и резус-фактора, например, комплект для определения группы крови КГК 01, который также применим и для выявления совместимости крови донора с кровью реципиента.
В набор обычно входит планшет, шпатель и штатив для сывороток.
Плюсы и минусы методов
Если говорить о каждом конкретном методе проверки группы крови, то можно выявить следующее:
- Плюс перекрёстного метода в его контрольной направленности, то есть он имеет особенность предотвращать главные ошибки при диагностировании группы крови другими стандартными способами;
- Плюс способа с применением цоликлонов заключается в его возможности применения в случаях, когда стандартные сыворотки не могут быть применены. Минус же заключается в сложности проведения, соблюдении всех условий для оптимального проведения процедуры;
- Эритротесты хороши тем, что доступны и для домашнего использования, но отрицательной их стороной считается неидеальная результативность, то есть итог может быть некорректным.
Перечисленные методики в общей характеристике в равной степени обладают теми или иными положительными и отрицательными сторонами.
Среди них можно выделить минусы:
- Возможность ошибки – даже при проведении сложной и оправданной методики могут появляться ошибочные результаты.
- Обязательное соблюдение правил – многие методики должны проводиться в специальных условиях, требующих тщательной подготовки и соблюдения определённых параметров помещения, его температуры и влажности. Реагенты должны корректно храниться, что тоже накладывает свои трудности на практику проведения исследования.
Среди плюсов выделяют:
- Многие из данных методик точны, позволяют получить правильный результат с точностью до 100% (особенно это касается способа с применением цоликлонов).
- Быстрота выполнения – для проведения анализа и ожидания времени воздействия реагентов на кровь не уходит много времени, обычно продолжительность реакции составляет не более 5-ти минут.
- Возможность определения родства при анализе крови на принадлежность к группе.
Достоверность методик
В некоторых случаях при определении группы крови могут возникать ошибки, имеющие различный характер.
Технические ошибки:
- Неправильное расположение реагентов — может нарушить корректность проведения анализа, так как спутаются все результаты. Перед применением важно изучить планшет с реагентами на наличие ошибок или некачественности самих реагентов.
- Несоблюдение температурного режима – исследование проводится при температуре не выше 25 градусов и не ниже 15 градусов, так как в крови могут содержаться агглютинаты, склеивающие эритроциты при недостатке тепла, а при его избытке антитела А, В и АВ могут терять свою активность.
- Нарушение количественного соотношения исследуемого материала и реагентов — приводит к ошибкам в результатах. Если количество эритроцитов значительно выше числа реагентов, агглютинация может пройти практически незаметно; если количества эритроцитов недостаточно, реакция проявляется слишком медленно и приводит к некорректной расшифровке результата.
- Несоблюдение времени наблюдения — приводит к некорректной расшифровке. Реакция может появиться спустя 10-15 секунд, что может быть рассмотрено в качестве результата, но для точной результативности важно выждать не менее 5-ти минут, так как слабый антиген А характеризуется замедленной реакцией.
- Несоблюдение подвижности смеси – при этом эритроциты могут осесть и дать неправильный результат при оценивании. Планшетную поверхность нужно постоянно покачивать.
Функциональные и другие ошибки:
- При определении трудноопределимой группы крови могут появиться ошибки. Так как эритроциты А2 низкоагглютинативны, их определение может вызвать ряд сложностей и появление последующих ошибочных результатов.
- Неспецифическая агглютинация эритроцитов – данное отклонение может наблюдаться у пациентов, страдающих анемией или иными аутоиммунными заболеваниями, у младенцев с гемолитическими патологиями.
- Неспецифическую агглютинацию можно спутать со специфической, поэтому для проверки проводится проба с сывороткой АВ. Делается это для корректного подбора донора.
- Наличие кровяных химер – эритроцитов, которые отличаются по показаниям, но находятся в одном кровяном русле. Возникает при частом переливании крови, у близнецов и после пересадки костного мозга.
- При наличии определённых патологий (цирроз печени, сепсис, ожоги) может наблюдаться повышенная агглютинация, что спутывает результаты анализов. При лейкозе обратная ситуация – снижение агглютинабельности.
Роль агглютинации важна в медицине.
С помощью неё выявляется группа крови, патологии. Подобные анализы крови помогают сохранить многим людям жизнь, так как правильный подбор всех параметров крови — резус-фактора и группы — очень важен при переливаниях и проведении оперативных вмешательств.
Вопрос-ответ
Почему японцы боятся 3 группы крови?
III группа (B) — эту группу условно называют «кочевниками». Японцы считают таких людей сильными, страстными, но неготовыми к рутине. Негативные качества: безответственность, непредсказуемость, эгоистичность. Они не умеют прощать и понимать.
Как называют людей с 4 группой крови?
Четвертая группа крови — ремесленники.
Советы
СОВЕТ №1
Перед проведением теста на определение группы крови, убедитесь, что вы используете качественные и сертифицированные наборы для тестирования. Это поможет избежать ошибок и получить точные результаты.
СОВЕТ №2
Если вы планируете сдавать анализ на группу крови в медицинском учреждении, заранее уточните, какие документы или направления могут понадобиться. Это сэкономит ваше время и сделает процесс более комфортным.
СОВЕТ №3
Не забывайте, что группа крови может изменяться в редких случаях, например, после переливания или трансплантации. Поэтому рекомендуется периодически проверять свою группу крови, особенно если вы планируете операции или другие медицинские процедуры.
СОВЕТ №4
Запишите свою группу крови и храните эту информацию в доступном месте, например, в медицинской карточке или на телефоне. Это может быть полезно в экстренных ситуациях, когда требуется быстрое переливание крови.